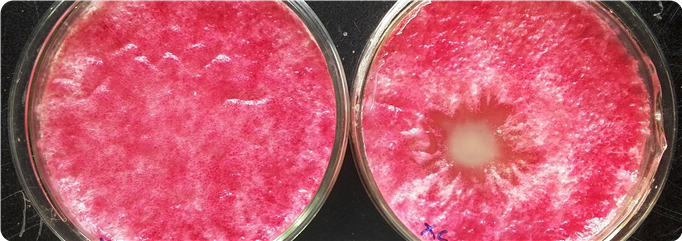

带毕业生也有三年了,有一些感触,也有一些无奈,最近在网上看到一篇吐槽,颇有些同感。未查询到原文出处,现转录如下: 一年里最紧...
ZL201510506178.8 一种杀优洛菌素链霉菌和含有杀优洛菌素链霉菌的杀菌剂及其制备方法和应用 本发明提供一种杀优洛菌素链霉菌和含有杀优洛...
本研究小组网站由中国农药学论坛提供技术支持和网络服务,网站资源与论坛共分享。 本网站部分资源来自于网络,在资源出处均有标示,...
研究小组网站启用网站图标ICO,开启小组网站时会在标签页和地址栏处显示以下图标。图标象征科研工作象幼苗一样需要精心呵护才能茁壮...